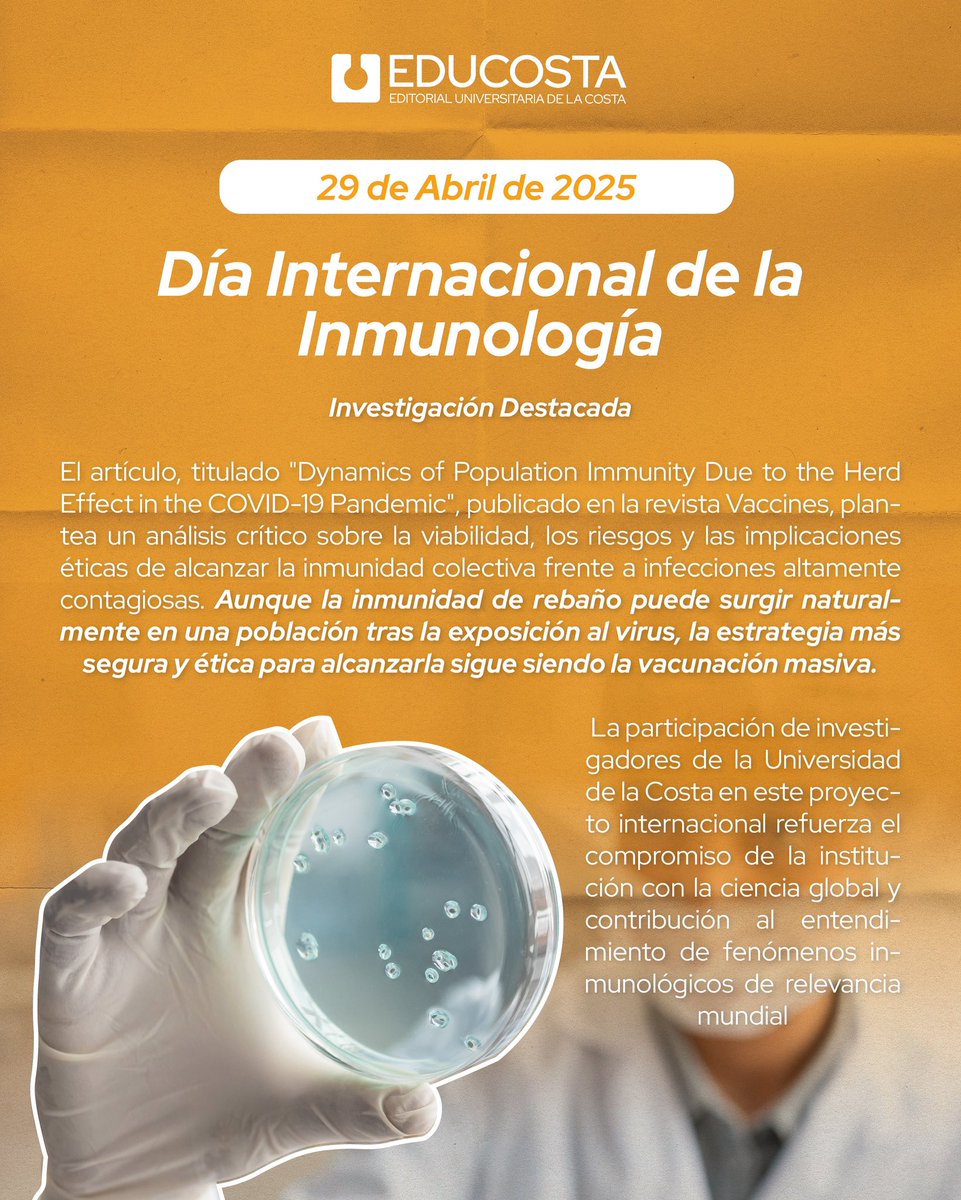

Universidad de la Costa
@unicostacol
Formamos ciudadanos integrales que contribuyen al desarrollo sostenible. Acreditada en ALTA CALIDAD. IES Vigilada Mineducación.
ID: 162539622
http://www.cuc.edu.co 04-07-2010 00:16:40
23,23K Tweet
12,12K Followers
391 Following



De las vainas chéveres de estar en Universidad de la Costa es conversar con los jóvenes de temas de inteligencia emocional, de relaciones, de aprender de los errores. Me alegran esos diálogos. Jader Igirio Edgardo Sánchez M, Ph.D T I T O Alcy Mb #Educación #Universidad


¡CELEBREMOS EL #DÍADELNIÑO!🎉👧🏼👦🏻 Este es un llamado pa’ todos los carnavaleritos a que se unan a esta agenda espectacular: 🚶🏻♂️Recorridos guiados con ‘Joselito Paco Paco’ en el Museo del Carnaval de Barranquilla. 🤩Show de Títeres con Baúl Polisémico. 🗣️Taller Lúdico ‘Voces del semillero del



La investigación fue liderada por: 📍 Universidad de Cartagena 📍 Universidad de la Costa 📍 Grupo ALZAK 🤝 Con el apoyo de Sanofi Colombia





Investigadores de Brasil, Túnez, Arabia Saudita y Colombia, incluida la Universidad de la Costa , publicaron hallazgos clave sobre la remoción de contaminantes eternos (PFAS) en la revista Colloids and Surfaces A. 📄 doi.org/10.1016/j.cols…



Un orgullo, 4 estudiantes de Comunicación Social, Unicosta están nominados con gran opción - Universidad de la Costa - Carnaval de Barranquilla #Posicionamiento


Nuestro rector Eduardo Crissien, fue galardonado con el Presidential Volunteer Service Award en EE. UU. por su labor y liderazgo en servicio comunitario. La ceremonia se realizó en el Trump National Doral, Miami. Un reconocimiento a líderes que transforman comunidades. 👏

Desde la Universidad de la Costa lamentamos profundamente los recientes hechos y reiteramos el acompañamiento a toda nuestra comunidad universitaria y sus familias.


📱🧠 Critinet-Challenge: educar para pensar críticamente en la era digital En su más reciente publicación, las docentes-investigadoras Viviana de la Hoz y Marylin Amador Salazar, de la Universidad de la Costa , presentan la estrategia Critinet-Challenge 🧵


📅 En el #Díamundialdelalactancia , un estudio con participación de la Universidad de la Costa resalta: 🍼 La lactancia mejora el coeficiente intelectual 🍼 Fortalece el sistema inmune 🍼Reduce el riesgo de TDAH y autismo 🔬Lee el art. Completo: mdpi.com/2227-9067/9/7/…



Universidad de la Costa anunció la reelección de Eduardo Crissien Borrero como rector para el periodo 2025-2028, consolidando su liderazgo en la proyección académica, investigativa y social de la institución. “Muy honrado y complacido de que los fundadores hayan confiado una vez más para

🔬 Una nueva investigación internacional —con participación de la Universidad de la Costa — demuestra que los polifenoles (de frutas y plantas) pueden prevenir el cáncer de piel. 🛡️ ¿Cómo? 🧵